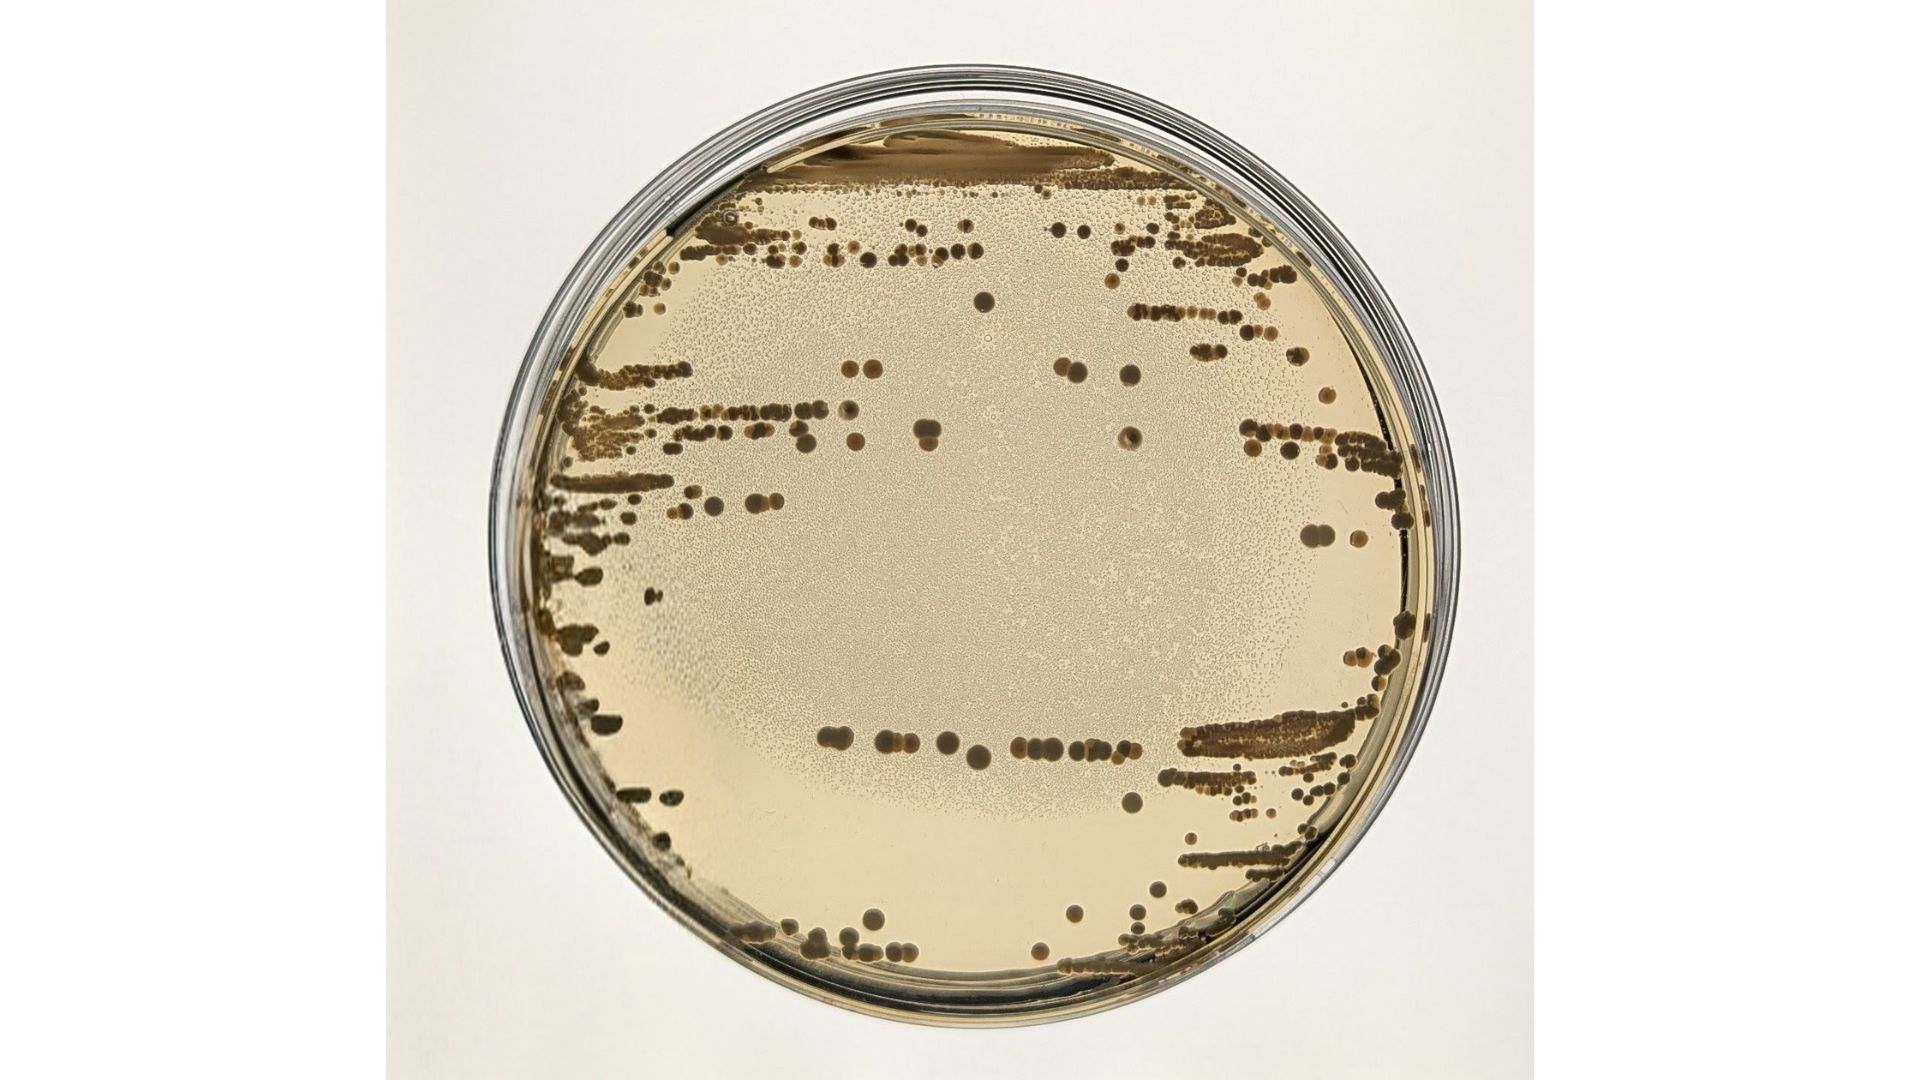
Imagen de placas de cultivo con cepas clínicas de Klebsiella pneumoniae. / CNB-CSIC

Mejorar la salud cardiovascular podría proteger la audición en mayores
Mejorar la salud cardiovascular podría proteger la audición en mayoresUn estudio identifica un nuevo mecanismo por el que los plásmidos pueden acelerar la aparición de resistencia a los antibióticos
Un estudio identifica un nuevo mecanismo por el que los plásmidos pueden acelerar la aparición de resistencia a los antibióticosNuevos datos satelitales permiten estimar con precisión el impacto climático del turismo en la Antártida
Nuevos datos satelitales permiten estimar con precisión el impacto climático del turismo en la AntártidaDescubren respuesta magnética inesperada en contactos atómicos de oro y plata
Descubren respuesta magnética inesperada en contactos atómicos de oro y plataRevelan una nueva plataforma para dispositivos que combinan magnetismo y superconductividad
Revelan una nueva plataforma para dispositivos que combinan magnetismo y superconductividadLa calidad de la dieta, clave para reducir el riesgo de múltiples enfermedades crónicas
La calidad de la dieta, clave para reducir el riesgo de múltiples enfermedades crónicasDefinen perfiles de riesgo para prevenir la revictimización en violencia de género
Definen perfiles de riesgo para prevenir la revictimización en violencia de géneroLa pubertad medieval era más larga y comenzaba más tarde que la actual
La pubertad medieval era más larga y comenzaba más tarde que la actualLas zonas verdes favorecen la diversidad y actividad de murciélagos en zonas urbanas
Las zonas verdes favorecen la diversidad y actividad de murciélagos en zonas urbanasPrimera red científica de litotecas arqueológicas para estudiar las rocas silíceas usadas en la prehistoria
Primera red científica de litotecas arqueológicas para estudiar las rocas silíceas usadas en la prehistoriaDesarrollan un método más limpio y barato para unir moléculas usando luz visible
Desarrollan un método más limpio y barato para unir moléculas usando luz visibleDemuestran que la arquitectura sináptica de los circuitos sensoriales cambia según el área de la corteza cerebral
Demuestran que la arquitectura sináptica de los circuitos sensoriales cambia según el área de la corteza cerebralEl afrontamiento positivo se asocia a una mayor resiliencia psicológica y puede entrenarse
El afrontamiento positivo se asocia a una mayor resiliencia psicológica y puede entrenarseEspaña consolida su liderazgo en investigación antártica tras 30 años de cooperación global
España consolida su liderazgo en investigación antártica tras 30 años de cooperación globalNuevas excavaciones en Abri du Maras confirman ocupaciones humanas de hace 200.000 años
Nuevas excavaciones en Abri du Maras confirman ocupaciones humanas de hace 200.000 añosControlan por primera vez la superconductividad en grafeno mediante ingeniería de interfaces
Controlan por primera vez la superconductividad en grafeno mediante ingeniería de interfacesMás de la mitad de los adultos mayores hispanos en EE. UU. presenta pérdida auditiva
Más de la mitad de los adultos mayores hispanos en EE. UU. presenta pérdida auditivaNuevo estudio revela cómo mutaciones específicas en BRCA2 alteran procesos clave en el cáncer
Nuevo estudio revela cómo mutaciones específicas en BRCA2 alteran procesos clave en el cáncerDescubren un ruido cuántico gigante que revela superconductividad oculta en materiales magnéticos
Descubren un ruido cuántico gigante que revela superconductividad oculta en materiales magnéticosUna dieta rica en micronutrientes se asocia con menor pérdida auditiva en personas mayores
Una dieta rica en micronutrientes se asocia con menor pérdida auditiva en personas mayores